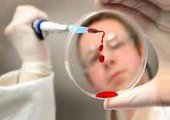

29.08.2014 19:33
Отдых в этих странах становится смертельно опасным из-за вспышки лихорадки Денге и малярии. Роспотребнадзор предупреждает российских туристов, что на юг и северо-восток Таиланда стали опасными для посещения.
Отдых в этих странах становится смертельно опасным из-за вспышки лихорадки Денге и малярии. Роспотребнадзор предупреждает российских туристов, что на юг и северо-восток Таиланда стали опасными для посещения.
За прошедшие с начала года 8 месяцев в Таиланде зарегистрировано более 10 тысяч случаев лихорадки Денге, известно о 5 летальных исходах. Так же около 11 тысяч человек пострадали от малярии, что в два раза превысило прошлогодние показатели.
В Таиланде правительством принимаются экстренные меры, но вероятность распространения эпидемии высока.
По этим же причинам неспокойно и в соседнем Китае, где в южно-китайском регионе Гуанчжоу к середине этого месяца было выявлено 400 больных лихорадкой Денге, причем 250 человек скончались.
Роспотребнадзор предлагают учесть эту информацию при планировании поездок за рубеж и обратить особое внимание на меры профилактики.
Фото: udoktora.net
Просмотров: 1313
Коментариев: 0
Прими участие в опросе, нам важно мнение каждого! Итоги и архив голосований








